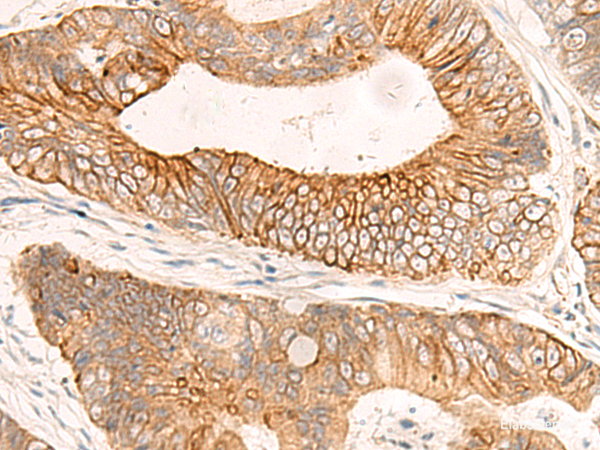
Immunohistochemistry of paraffin-embedded Human colorectal cancer tissue  using ABHD2 Polyclonal Antibody at dilution of 1:50(×200)

Elabscience
SKU:E-AB-53414
ABHD2 Polyclonal Antibody
ABHD2 Polyclonal Antibody
Couldn't load pickup availability
ABHD2 Polyclonal Antibody
Introducing the ABHD2 Polyclonal Antibody, a highly efficient and reliable tool for various scientific applications. This product is available in a convenient size of 200μL, ensuring an ample supply for your research needs. With a concentration of 1.5 mg/mL, this antibody offers exceptional sensitivity and specificity, enabling accurate and precise detection of ABHD2 protein.
Crafted with utmost precision and quality, this polyclonal antibody has undergone rigorous testing to ensure optimal performance. It has been meticulously designed to target ABHD2, a crucial protein involved in various biological processes.
The ABHD2 Polyclonal Antibody is suitable for a wide range of applications, including immunohistochemistry, western blotting, and immunofluorescence. Its versatility allows for seamless integration into your experimental protocols, providing reliable and reproducible results.
With its exceptional performance and high affinity, this antibody guarantees superior detection and quantification of ABHD2 protein in your samples. Its robust nature ensures minimal background noise, enhancing the accuracy and reliability of your experimental data.
In summary, the ABHD2 Polyclonal Antibody is an indispensable tool for researchers seeking to unravel the intricate mechanisms involving ABHD2 protein. Its superior quality, reliability, and versatility make it an ideal choice for various scientific applications. Trust in this antibody to deliver exceptional results and advance your research endeavors.
Share